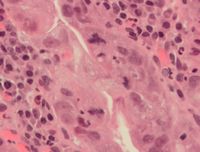

انقسام فتيلي


a. non-dividing cells
b. nuclei preparing for division (spireme-stage)
c. dividing cells showing mitotic figures
e. pair of daughter-cells shortly after division
الانقسام الفتيلي أو الانقسام المغزلي أو الانقسام الخيطي أو التفتل Mitosis هو العملية الحيوية التي يتم بها تضاعف المعلومات الوراثية الجينية ضمن الخية الحية لتشكيل خليتين حيتين متطابقتين ندعوهما الخليتين الابنتين . عادة الانقسام الفتيلي يتبع بحرائك حلوية تعمل على قسم السيتوبلاسم و الغشاء الخلوي للخلية الأم بين الخليتين الابنتين . مما يؤدي إلى خليتين ابنتين متطابقتين تماما بتوزيع متطابق تقريبا للعضيات الخلوية و المكونات الخلوية الأخرى. الانقسام الفتيلي والحرائك الخلوية معا تشكلان ما يدعى الطور الفتيلي mitotic (M) phase من دورة حياة الخلية cell cycle، انقسام الخلية الأم إلى خليتين ابنتين، كل واحدة تملك نسخة جينية مطابقة لنسخة الخلية الأم. يحدث الانقسام الفتيلي كثيرا في الالخلايا حقيقيات النوى. في المتعضيات متعددة الخلايا، تخضع الخلية الجسدية للانقسام الفتيلي ، في حين أن الخلايا العروس (التي يقدر لها ان تتحول لنطاف و بييضات) تخضع انقسام انتصافي meiosis ، أما الخلايا طلائعية النوى قتنقسم بعملية تسمى الانشطار الثنائي Binary fission .
مراحل الانقسام الفتيلي
تمر الخلية الجسمية في دارتها الانقسامية في أربعة أطوار متميزة، هي: الطور G1 وفيه تتهيأ الخلية لتركيب الدنا، ثم الطور S synthesis) = التركيب) وفيه يتم فعلاً تركيب الدنا وتتضاعف الصبغيات (بتضاعف الدنا)، ثم الطور G2 وفيه تتهيأ الخلية للانقسام، ثم الطور 88 mitosis) = تفتل) إذ يتم الانقسام الخيطي. وتعرف الأطوار G1 وS وG2 باسم الطور البيني Interphase الذي يعد طور تركيب الدنا DNA synthesis، أي الطور S، من أهم مراحل هذا الطور البيني. وعند اقتراب الخلية من الانقسام تحصل تغيرات أساسية في السيتوبلازمة وفي النواة معاً.[1]

ففي السيتوبلازمة يبدأ المغزل بالتشكل اعتباراً من كرتي المُريكزين Centriol اللتين تتوضعان في القطبين المتقابلين للخلية، تشع منها ألياف في كل الاتجاهات. والألياف التي تتجه نحو مركز الخلية ليلاقي بعضها بعضاً وتشكل مغزلاً تؤدي دوراً مهماً في انقسام النواة.
وفي الوقت نفسه تحصل تبدلات عميقة داخل النواة. ففي البداية تصبح النواة حبيبية المظهر. ولكن هذه الحبيبيات لا تلبث أن تنصهر في عدد من الخيوط الطويلة والدقيقة جداً هي الصبغيات. وهنا يبدأ الدور الأول من الانقسام الخيطي (الشكل ـ3).
الطور التمهيدي
تظهر الصبغيات نتيجة تلولب الخييطات النووية المكونة للمادة الوراثية حيث تبدو في شكل عصيات تسمى الصبغيات. يتكون كل صبغي من وحدتين تسميان صبيغيين يرتبطان في مستوى الجزيء المركزي. ويتميز هذا الطور باختفاء النوية وتلاشي الغشاء النووي وبظهور مغزل الانقسام.
الطور الاستوائي
يبدأ الطور الاستوائي بتقاصر الصبغيات التي يوجد منها عدد مضاعف، يرمز إليه عادة بـ (2ن)، لتصير في نهاية هذا الدور بشكل عصي قصيرة. ثم تتقلص النوية وتذبل وتختفي مع اختفاء الغشاء النووي. ويكشف البحث الدقيق في هذه المرحلة أن كل صبغي يكون مؤلفاً من بنية مضاعفة ومن خيطين مثيلين identical وينطبق كل منهما على الآخر بشدة. ويسمى كل منهما الصُبَيْغي (الكروماتيد Chromatid). ويحتوي كل منهما على المادة الوراثية نفسها والتناسق نفسه. والحقيقة أن أحد الصُبَيْغيين هو نسخة عن الآخر الذي نسخه. وهذا النسخ أو التضاعف يشكل العملية الأساسية للحياة، إذ إن كل مورثة تمتلك إمكانية نسخ مورثة أخرى مماثلة لها كل التماثل. وينفصل صُبَيْغياً كل صِبغِي أحدهما عن الآخر ولكنهما يبقيان متصلين معاً في نقطة واحدة هي القُسَيْم المركزي centriomere الذي يشغل مكاناً ثابتاً في كل صِبغِي. والقُسَيْم المركزي سيربط أيضاً الصِبغِي إلى المغزل الذي يقود القسيم، في مرحلة تالية، مع الصبغي إلى كل من قطبي الخلية. وهكذا تتوضع الصبغيات في المستوى الاستوائي للخلية، في منتصف المغزل. وهذه هي طليعة الدور التالي Prometaphase.
الطور الانفصالي

تنقسم الجزيئات المركزية ويفترق صبيغيان عن بعضهما البعض. ثم يهاجر كل ضبغي ابن غلى أحد قطبي الخلية، وبذلك تتكون مجموعتان متماثلتان من الصبغيات ومماثلتان لصبغية الخلية الأم إذ يكون لكل صبغي من خلية الأم صبغي ابن مماثل في كل مجموعة. وتظهر فيه لُييْفات المغزل، التي ترتبط في الخلايا الحيوانية بالمريكزين المتوضعين في قطبي الخلية، على حين لا تكون هذه المريكزات موجودة في الخلايا النباتية.
وعندما تصل الخلية إلى هذه المرحلة تصطف الصبغيات خطياً في مركز الخلية، وتكون قسيماتها المركزية موزعة على محيط اللوحة الاستوائية التي تسمى لوحة الانقسام. وعندما تصل الصبغيات في انكماشها إلى الحد الأقصى تكون الخلية قد وصلت في انقسامها إلى الدور الثالث الذي يسمى دور الصعود.
الطور التالي

تفقد صبغيات كل مجموعة فرديتها مشكلة صبغين لنواة جديدة، ويختفي مغزل الانقسام ويتكون غشاء سيليلوزي (الغشاء الهيكلي)في وسط الخلية الأم حيث يقسمها إلى خليتين بنتين متماثلتين وراثيا ومماثلتين للخلية الأم.
طور الصعود
وهو يبدأ حين ينشطر القسيم المركزي طولياً. وينفصل كل صبغي عن قرينه انفصالاً تاماً، ويدعى عندها بالصبغي. وتبدأ هذه الصبغيات بالحركة باتجاه قطبي الخلية بهدف فصل مجموعة كاملة من الصبغيات الأخوية لتتوضع في كل من قطبي الخلية. ويمثل كل من هاتين المجموعتين العدد الصبغي المضاعف (2ن) لكلٍ من النواتين البنتين. وعندها تباشر هذه الصبغيات بالاسترخاء والتطاول استعداداً للدور الانتهائي.
الطور الإنتهائي
اكتمال هجرة الصبغيات إلى قطبي الخلية، وبذلك تتشكل مجموعة صبغية مضاعفة كاملة في كل من القطبين، كل منهما تماثل الأخرى وراثياً.
- تشكل غشاء نووي جديد حول كل من المجموعتين الصبغيتين.
- تشكل النوية أو النويات تشكلاً جديداً.
- اختفاء لييفات المغزل.
- استرخاء الصبغيات وتطاولها حتى تصير غير مرئية بالمجهر الضوئي.
- حصول الانقسام السيتوبلازمي وتشكل خليتين بنتين متماثلتين وراثياً ومماثلتين أيضاً للخلية الأم، تحوي كل منهما (2ن) صبغياً، هو 46 عند الإنسان.
Cytokinesis
الأهمية
Mitosis is important for the maintenance of the chromosomal set; each cell formed receives chromosomes that are alike in composition and equal in number to the chromosomes of the parent cell.
Mitosis occurs in the following circumstances:
- Development and growth
- The number of cells within an organism increases by mitosis. This is the basis of the development of a multicellular body from a single cell, i.e., zygote and also the basis of the growth of a multicellular body.
- Cell replacement
- In some parts of body, e.g. skin and digestive tract, cells are constantly sloughed off and replaced by new ones. New cells are formed by mitosis and so are exact copies of the cells being replaced. In like manner, red blood cells have short lifespan (only about 4 months) and new RBCs are formed by mitosis.
- Regeneration
- Some organisms can regenerate body parts. The production of new cells in such instances is achieved by mitosis. For example, starfish regenerate lost arms through mitosis.
- Asexual reproduction
- Some organisms produce genetically similar offspring through asexual reproduction. For example, the hydra reproduces asexually by budding. The cells at the surface of hydra undergo mitosis and form a mass called a bud. Mitosis continues in the cells of the bud and this grows into a new individual. The same division happens during asexual reproduction or vegetative propagation in plants.
تغيرات شكل الخلية أثناء الانقسام الفتيلي

In animal tissue, most cells round up to a near-spherical shape during mitosis.[2][3][4][5] In epithelia and epidermis, an efficient mitotic rounding process is correlated with proper spindle alignment and subsequent correct positioning of daughter cells.[4][5][6][7] Moreover, researchers have recently found that if rounding is heavily suppressed it may result in spindle defects, primarily pole splitting and failure to efficiently capture chromosomes.[8] Therefore rounding may play a protective role in ensuring accurate mitosis.[7][9]
أخطاء وتنويعات الانقسام الفتيلي
Errors can occur during mitosis, especially during early embryonic development in humans.[10] Mitotic errors can create aneuploid cells that have too few or too many of one or more chromosomes, a condition associated with cancer.[11]
خط زمني بالصور
Mitotic cells can be visualized microscopically by staining them with fluorescent antibodies and dyes.
طالع أيضاً
المصادر
- ^ محيي الدين عيسى. "الانقسام الخلوي". الموسوعة العربية. Retrieved 2011-06-16.
- ^ خطأ استشهاد: وسم
<ref>
غير صحيح؛ لا نص تم توفيره للمراجع المسماةMcConnell1930
- ^ خطأ استشهاد: وسم
<ref>
غير صحيح؛ لا نص تم توفيره للمراجع المسماةSauer1935
- ^ أ ب خطأ استشهاد: وسم
<ref>
غير صحيح؛ لا نص تم توفيره للمراجع المسماةMeyer2011
- ^ أ ب خطأ استشهاد: وسم
<ref>
غير صحيح؛ لا نص تم توفيره للمراجع المسماةLuxenburg2011
- ^ خطأ استشهاد: وسم
<ref>
غير صحيح؛ لا نص تم توفيره للمراجع المسماةNakajima2013
- ^ أ ب خطأ استشهاد: وسم
<ref>
غير صحيح؛ لا نص تم توفيره للمراجع المسماةCadart2014
- ^ خطأ استشهاد: وسم
<ref>
غير صحيح؛ لا نص تم توفيره للمراجع المسماةLancaster2013
- ^ خطأ استشهاد: وسم
<ref>
غير صحيح؛ لا نص تم توفيره للمراجع المسماةLancaster2014
- ^ Mantikou, E.; Wong, K.M.; Repping, S.; Mastenbroek, S. (December 2012). "Molecular origin of mitotic aneuploidies in preimplantation embryos". Biochimica et Biophysica Acta - Molecular Basis of Disease. 1822 (12): 1921–1930. doi:10.1016/j.bbadis.2012.06.013. PMID 22771499.
- ^ خطأ استشهاد: وسم
<ref>
غير صحيح؛ لا نص تم توفيره للمراجع المسماةDraviam2004
قراءات اضافية
- Morgan DO (2007) "The Cell Cycle: Principles of Control" London: New Science Press.
- Alberts B, Johnson A, Lewis J, Raff M, Roberts K, and Walter P (2002). "Mitosis". Molecular Biology of the Cell. Garland Science. Retrieved 2006-01-22.
{{cite web}}
: CS1 maint: multiple names: authors list (link) - Campbell, N. and Reece, J. (2001). "The Cell Cycle". Biology (6th ed. ed.). San Francisco: Benjamin Cummings/Addison-Wesley. pp. 217–224. ISBN 0-8053-6624-5.
{{cite book}}
:|edition=
has extra text (help); Unknown parameter|month=
ignored (help)CS1 maint: multiple names: authors list (link) - Cooper, G. (2000). "The Events of M Phase". The Cell: A Molecular Approach. Sinaeur Associates, Inc. Retrieved 2006-01-22.
- Freeman, S (2002). "Cell Division". Biological Science. Upper Saddle River, NJ: Prentice Hall. pp. 155–174. ISBN 0-13-081923-9.
- Lodish H, Berk A, Zipursky L, Matsudaira P, Baltimore D, Darnell J (2000). "Overview of the Cell Cycle and Its Control". Molecular Cell Biology. W.H. Freeman. Retrieved 2006-01-22.
{{cite web}}
: CS1 maint: multiple names: authors list (link) - Maton, Anthea (1997). Cells: Building Blocks of Life. New Jersey: Prentice Hall. pp. 70–74. ISBN 0-13423476-6.
{{cite book}}
: Unknown parameter|coauthors=
ignored (|author=
suggested) (help)
وصلات خارجية
- Science aid: Mitosis and meiosis: A simple account of the mitotic and meiotic processes.
- Mitosis Animation.
- Mitosis (Flash Animation)
- Video of a live amphibian lung cell undergoing mitosis.
- A Flash animation comparing Mitosis and Meiosis